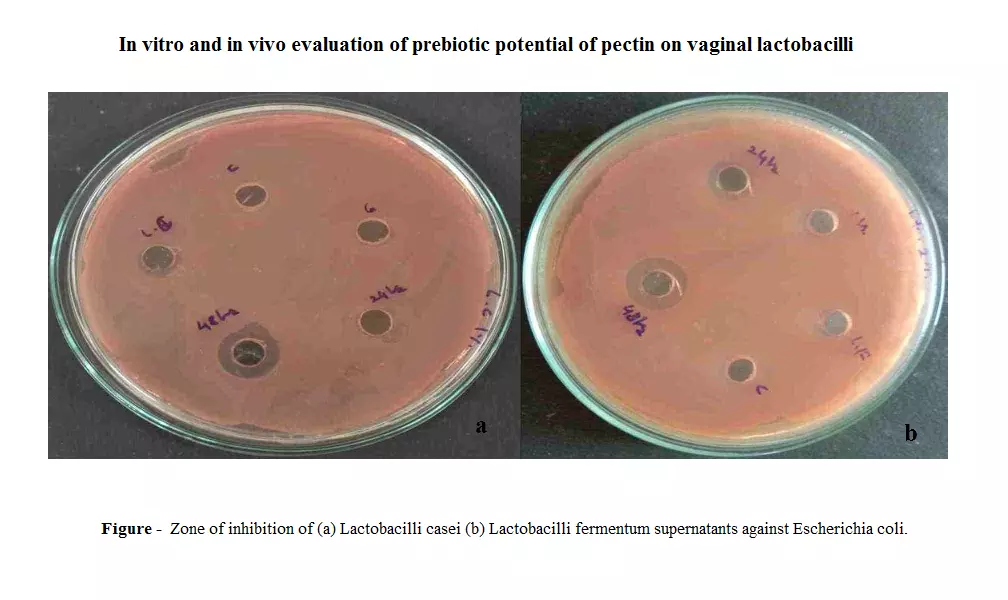
Graphical Abstract

In vitro and in vivo evaluation of prebiotic potential of pectin on vaginal lactobacilli
Sanjeevani Shekhar Deshkar, Kiran Suresh Ahire, Jayashri Gajanan Mahore
DOI: 10.7324/JABB.2021.100113Pages: 103-111

In vitro and in vivo evaluation of prebiotic potential of pectin on vaginal lactobacilli
Sanjeevani Shekhar Deshkar, Kiran Suresh Ahire, Jayashri Gajanan Mahore
DOI: 10.7324/JABB.2021.100113Pages: 103-111